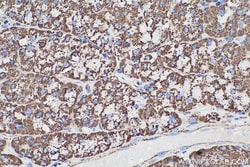
ETFA Mouse Monoclonal Antibody, Proteintech Unconjugated; 20 &mu;L:Anticorps,

missing translation for 'onlineSavingsMsg'
Learn More
Learn More
ETFA Mouse Monoclonal Antibody, Proteintech
Mouse Monoclonal Antibody
Marque: Proteintech 67661-1-IG-20UL
Les retours ne sont pas autorisés pour ce produit.
Afficher la politique du retour.
Description
The ETFA antibody from Proteintech is a mouse monoclonal antibody generated with recombinant protein of human ETFA. This antibody recognizes human, mouse, rat, pig antigen. The ETFA antibody has been validated for the following applications: WB, IHC, IF/ICC, ELISA analysis.Spécification
| ETFA | |
| Monoclonal | |
| 1000 μg/mL | |
| EMA; GA2; MADD | |
| Recombinant Protein | |
| 20 μL | |
| Primary | |
| Human, Mouse, Rat, Pig | |
| 30 kDa | |
| Liquid |
| Western Blot, Immunohistochemistry, Immunocytochemistry/Immunofluorescence, ELISA | |
| 3C12G5 | |
| Unconjugated | |
| Mouse | |
| Protein A purification | |
| RUO | |
| 2108 | |
| Store at -20°C. Stable for one year after shipment. | |
| Monoclonal Antibody | |
| IgG2a |
Correction du contenu d'un produit
Veuillez fournir vos retours sur le contenu du produit en remplissant le formulaire ci-dessous.
Nom du produit
Vous avez repéré une opportunité d'amélioration ?Partager une correction de contenu